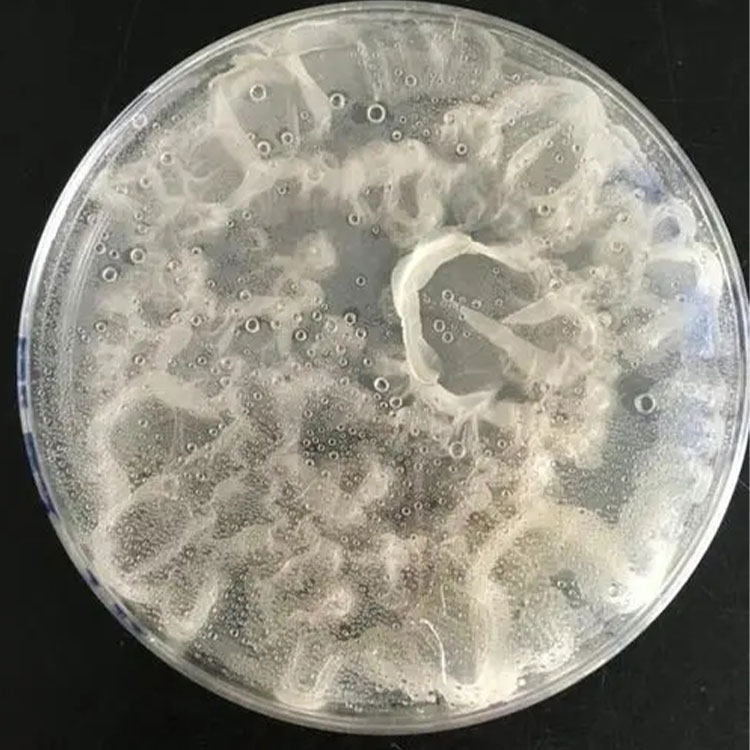

商铺名称:山东碧蓝生物科技有限公司
联系人:王将(先生)
联系手机:
固定电话:
企业邮箱:409215763@qq.com
联系地址:山东省泰安市经济开发区创业大街28号
邮编:271411
联系我时,请说是在汽配名企网上看到的,谢谢!
商品详情
| 产品参数 | |||
|---|---|---|---|
| 地衣芽孢杆菌 1000亿cfu/g 动保 养殖 微生物菌剂 益生菌温蕴现货 是否进口 | 否 | ||
| 包装规格 | 20 | ||
| 产品名称 | 地衣芽孢杆菌 | ||
| 剂型 | 粉末 | ||
| 执行标准 | 国标 | ||
| 主要用途 | 饲料添加 | ||
| 加工定制 | 是 | ||
| 地衣芽孢杆菌厂家 | 山东碧蓝生物 | ||
| 地衣芽孢杆菌运输 | 物流 | ||
| 地衣芽孢杆菌颜色 | 棕 | ||
| 地衣芽孢杆菌保质期 | 12个月 | ||
| 发货保护 | 封闭保护 | ||
| 饲料添加剂生产许可证编号 | 鲁饲添(2023)H09471 | ||
| 品牌 | 碧蓝生物 | ||
| 有效物质含量 | 地衣芽孢杆菌% | ||
.jpg)
.jpg)
.jpg)
.jpg)
.jpg)
.jpg)
.jpg)
.jpg)
.jpg)
.jpg)
.jpg)
.jpg)
.jpg)
.jpg)
.jpg)


